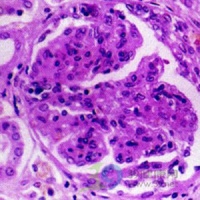

紫癜性肾炎
紫癜性肾炎是指过敏性紫癜引起的肾脏损害,其病因可为细菌、病毒及寄生虫等感染所引起的变态反应,或为某些药物、食物等过敏,或为植物花粉、虫咬、寒冷刺激等引起。临床表现除有皮肤紫癜、关节肿痛、腹痛、便血外,主要为血尿和蛋白尿,多发生于皮肤紫癜后一个月内,有的或可以同时并见皮肤紫癜、腹痛,有的仅是无症状性的尿异常。如果蛋白丢失过多,亦可出现肾病综合征的表现,如果血尿、蛋白尿长期持续存在,亦可伴有肾功能减退,最后导致慢性肾功能衰竭。过敏性紫癜导致肾受累的比例为20%~100%,男性患者多于女性。
诊断标准[编辑 | 编辑源代码]
I 度:为微小病变。
II 度:为系膜增生。
III 度:(a)局灶性和 (b)弥漫性增生或硬化,新月体形成<50%。
IV 度: (a)局灶性和 (b)弥漫性系膜增生或硬化,新月体形成50%~75%。
V 度: (a)局灶性和b(a)弥漫性系膜增生或硬化,新月体形成>75%。
VI 度:膜性增生性病变。
2.世界卫生组织(WHO)病理分级
I: 包括微小病变,微小病变伴局灶节段性显著,局灶性增生性肾小球肾炎轻度。
II:包括弥漫性增生性肾小球肾炎轻度,弥漫性增生性肾小球肾炎轻度伴局灶节段性显著。
III:包括局灶性增生性肾小球肾炎中等度,弥漫性增生性肾小球肾炎中等度。
IV:包括弥漫性增生性肾小球肾炎重度,终末期肾。
中医辨证[编辑 | 编辑源代码]
中医文献中对皮肤出现紫色斑点等,一般归属于“斑疹”门中,由于过敏性紫癜在病初常有外感,因过敏引起,故其病因多与风、湿、热、毒邪有关。本病中医一般归于“斑疹”、“瘀斑”类进行辨证。紫癜性肾炎其病机可以认为是患者素有血热内蕴,外感风邪或食物有动风之品,风热相搏或热毒炽盛,如灼伤血络,以致迫血妄行,外溢肌朕,内迫胃肠,甚则及肾,故有下肢皮肤紫痈、腹痛频作,甚则便血、尿血。如属虫咬后,局部红肿水泡,为虫毒浸淫所致,湿毒化热,阻于络脉,气血循行不畅,迫血妄行,故亦可出现紫癜,甚则尿血。如寒邪外侵,内滞于血络,亦可发为紫癜,气不摄血或虚火灼络,均可出现尿血。
常见偏方[编辑 | 编辑源代码]
1.紫癜肾合剂:当归10g,白芍10g,生地15g,黄芪15g,党参10g,丹皮10g,炙龟板15g,犀角6g,白茅根10g,炒栀子10g,木通6g,车前草10g,阿胶10g(烊化),甘草6g。水煎空腹服,日1剂,分2次服。治疗本病属湿热下注者。
2.消斑汤:生地10g,丹皮9g,当归10g,白芍12g,紫草10g,蝉衣9g,防风10g,白茅根30g,炒蒲黄3g,金银花10g。水煎服,日1剂,分2次服。治疗本病血尿明显者。
3.五草消毒饮:白花蛇舌草15g,益母草15g,紫草30g,旱莲叶15g,仙鹤草15g,野菊花30g,地肤子30g,白茅根15g。水煎服,日1剂,分2次服。治疗本病见血尿浮肿者。
4.清热活血方:益母草30g,白茅根30g,荠菜花15g,金银花9g,连翘9g,大小蓟9g,王不留行籽12g,三七粉 (吞服)2g。水煎服,日1剂,分2次服。治疗本病属血热挟瘀者。
预防保健[编辑 | 编辑源代码]
生活护理:促进身心休息,如肾性高血压者应定时测血压,根据血压变化情况增加卧床休息时间。注意口腔的护理:早晚及餐后应口,保持口腔清洁,去除口臭,减少恶心,防止细菌和霉菌生。
合理的膳食:饮食方面应根据每种疾病的情况对患者进行具体的饮食指导,如肾功能不全时,应摄高热量(以糖为主),优质低蛋白饮食,限进液量,保持水平衡。
肾病患者大多都限制摄入高蛋白食物,对于饮食方面的营养补充也存在一些问题,如精神压力及本身经济条件的限制,食欲不振等因素,使得机体各方面比较虚弱,容易引起感冒、胃肠道感染等。
如果进行适当的运动锻炼,不仅可以增强机体的抗病能力,保持一种愉快的心情,而且在一定程度上增加进食量,对于营养不良,缺乏蛋白质引起的肌肉萎缩,也有一定的改善。
控制糖尿病因糖尿病患者的血管慢慢地会硬化,尤其末稍微血管。肾脏是由数百万细微的血管组成的,糖尿病严重时,肾脏的功能也可能损坏了。据统计有四分至五分的"洗肾"病人是由糖尿病末期引起的。
经常做肾功能检查每半年就必须做一次尿液筛检检、血压的检测。几乎-半的肾脏病人肾脏损坏过程是在不知不觉中进行的,所以等到身体感到不适时很可能已经已到了肾脏病的末期--需靠洗肾生存的时候了
伴随病症[编辑 | 编辑源代码]
皮疹[编辑 | 编辑源代码]
皮疹是一种皮肤病变。从单纯的皮肤颜色改变到皮肤表面隆起或发生水疱等有多种多样的表现形式。常为起病时的首先表现,紫癜大小不等,高出皮肤表面,呈紫红色,压之不退色,可融合成片,或呈疱疹状、荨麻疹样或多形性红斑,并可伴神经性水肿。
严重时偶可发生溃疡和坏死。紫癜多见于四肢伸侧和臀部,以下肢和踝、膝等关节处较为明显,呈对称性分批出现,易反复发作。
关节症[编辑 | 编辑源代码]
紫癜性肾炎患者的关节症状多数以游走性多发性关节痛为特征。常见受累关节是膝、踝和手。症状多于数日内消退,不遗留关节变形。 部分患儿有关节肿痛,多累及大关节,如膝、踝、腕、肘等,小关节不受累。可单发,多发或呈游走性。关节肿胀、疼痛,活动时疼痛加重,局部常伴微热,重者有灼热感。关节症状消退后无后遗症。
泌尿系统症[编辑 | 编辑源代码]
多数紫癜性肾炎患儿表现为尿中有少量蛋白及显微镜下有红细胞,有时见有管型,亦可出现肉眼血尿。一般预后佳,偶呈急进性肾炎经过,发展为急性肾功能衰竭者,预后不良。部分患儿有大量蛋白尿,血尿、浮肿、高血压、低蛋白血症和高胆固醇血症等为肾病综合征。
其它[编辑 | 编辑源代码]
胃肠道
紫癜性肾炎患者的胃肠道表现最常见为腹痛,以脐周和下腹为主,阵发性绞痛。可伴有恶心呕吐及血便,偶见吐血。儿童紫癜性肾炎有时可并发肠套叠、肠梗阻和肠穿孔。
高血压
紫癜性肾炎引发的高血压约占高血压患者的20%~40%,血压一般为轻度至中度增高,个别紫癜性肾炎患者的病例可出现高血压脑病。高血压常与尿异常同时发现,不过多数紫癜性肾炎患者恢复较快。
| |||||||||||||||||||||||||||||||||||||||||||